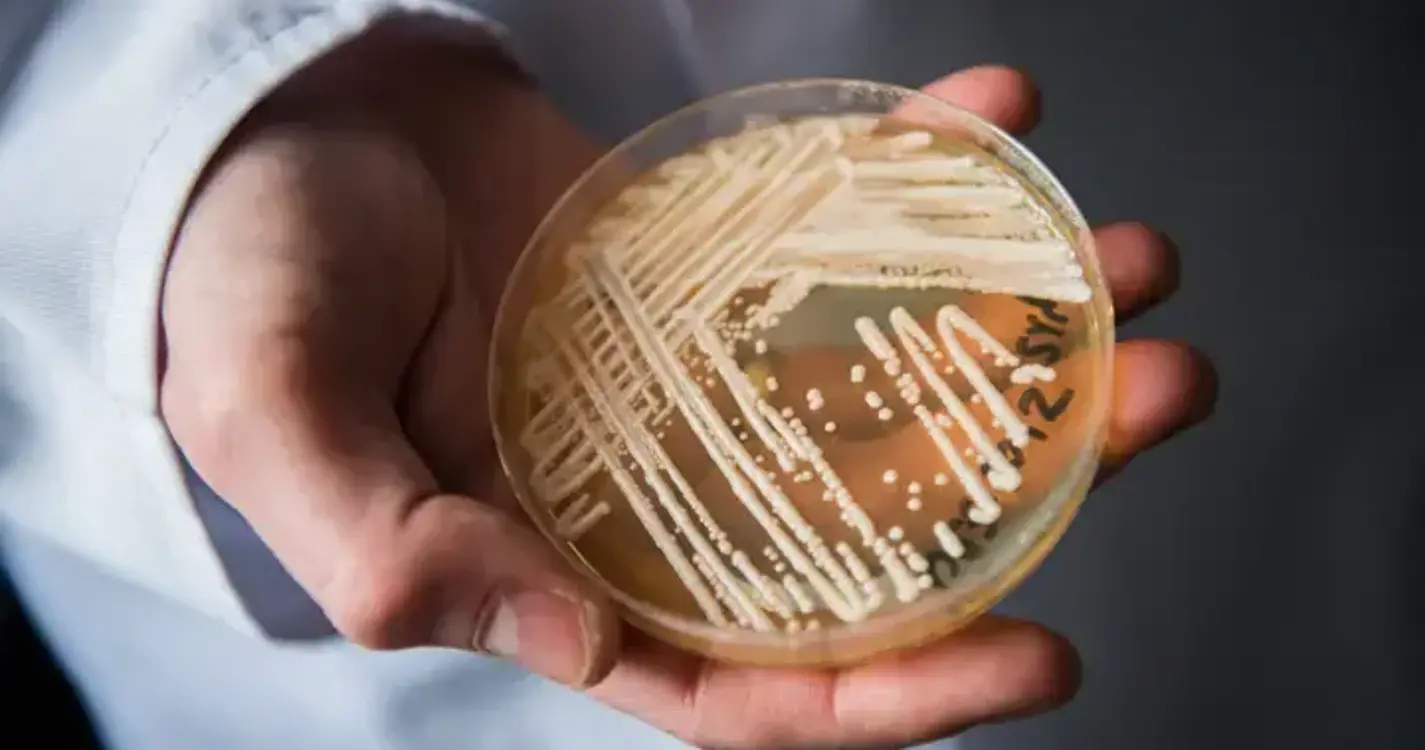
Estudo identifica primeiros casos de ‘Candida auris’ em Portugal e reforça importância da vigilância

Estudo identifica primeiros casos de ‘Candida auris’ em Portugal e reforça importância da vigilância
Uma equipa de investigadores liderada pela Faculdade de Medicina da Universidade do Porto (FMUP) estudou os primeiros casos confirmados em Portugal de infeção por ‘Candida auris’, um fungo resistente a medicamentos considerado uma ameaça à saúde pública global.
Num comunicado enviado hoje à agência Lusa, a FMUP descreve que este estudo identifica os primeiros casos de ‘Candida auris’ no país, resultando em conclusões que reforçam a importância da vigilância hospitalar.
“É fundamental que as instituições dedicadas ao ensino e à investigação se articulem com os hospitais e ULS [Unidades Locais de Saúde], no sentido de uma investigação translacional integrada, de modo a reforçar a capacidade de resposta a desafios emergentes em saúde pública com base em evidência”, defende Sofia Costa de Oliveira, docente da FMUP que coordenou o estudo, cujos resultados foram publicados na revista científica Journal of Fungi em outubro de 2025.
Foram classificados oito casos identificados em 2023, num hospital da região Norte, lê-se no resumo partilhado com a Lusa, no qual é salvaguardado que “nenhuma das três mortes dos casos de infeção invasiva reportados esteve exclusivamente associada à infeção, mas sim a comorbilidades severas dos doentes”.
Sublinhando que “é importante perceber que este fungo é de propagação hospitalar e não comunitária”, a coordenadora refere que “a sua relevância em saúde pública está associada principalmente à facilidade de transmissão em unidades de cuidados de saúde e à resistência a alguns antifúngicos, o que justifica uma vigilância reforçada”.
“A deteção precoce de colonização ou infeção em doentes em risco permite uma intervenção mais eficaz e limita a propagação nos serviços de saúde. As medidas de controlo de infeção, como a higiene rigorosa das mãos, a desinfeção de superfícies e equipamentos e a vigilância laboratorial, são cruciais para reduzir a transmissão”, conclui.
A ‘Candida auris’ é uma levedura que pode colonizar a pele e causar infeções invasivas em doentes com fatores de risco, como doenças graves, tratamentos invasivos e uso de antibióticos e imunossupressores. Considerada uma ameaça à saúde pública global, está disseminada em vários continentes, atingindo cerca de 60 países.
O microrganismo não é transmitido pelo ar, mas sim por contacto entre doentes, entre profissionais de saúde, ou com superfícies e equipamentos contaminados.
Esta espécie distingue-se pela resistência a múltiplos fármacos antifúngicos e pela capacidade de persistir em superfícies e equipamentos, o que pode facilitar a transmissão em unidades de cuidados de saúde.
“A caracterização dos mecanismos envolvidos na resistência à terapêutica antifúngica é fundamental para investigar alternativas farmacológicas mais eficazes. O próximo passo será explorar o impacto real das novas mutações detetadas na progressão da infeção e na resistência antimicrobiana da ‘Candida auris’, de forma a tentar controlar esta ameaça global para a saúde”, defende a professora.
O artigo resultou de um trabalho de investigação que também juntou Isabel Miranda, da FMUP e RISE-Health, Dolores Pinheiro, José Artur Paiva e João Tiago Guimarães, da FMUP e da ULS São João, Micael Gonçalves, do CESAM, e Sandra Hilário, da FCUP.
Em setembro do ano passado, o Centro Europeu de Prevenção e Controlo das Doenças (ECDC) alertou para a rápida propagação nos hospitais deste fungo resistente a medicamentos e pediu medidas para travar a sua disseminação.
Em comunicado, o ECDC indicou que, entre 2013 e 2023, foram registados mais de 4.000 casos nos países da UE/EEE (inclui a Islândia, o Liechtenstein e a Noruega), destacando “um salto significativo” em 2023, ano em que foram divulgados 1.346 casos em 18 países.